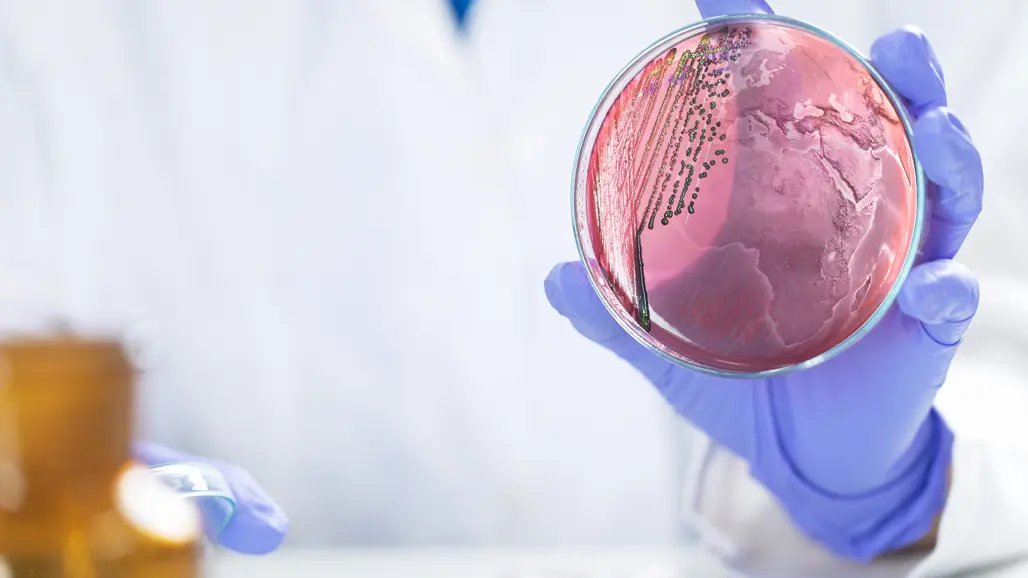

One health
Att hantera komplexa hälsoutmaningar kräver ett One Health-perspektiv. Genom att integrera kunskap från human-, djur- och miljöhälsa kan vi förbättra livsmedelssäkerheten, förebygga sjukdomar och utveckla effektiva, tvärvetenskapliga insatser.
One Health är ett enat, integrerat angreppssätt för att på ett hållbart sätt balansera och optimera hälsan hos människor, djur och ekosystem. Det bygger på insikten att hälsan hos människor, tama och vilda djur, växter och den omgivande miljön (inklusive ekosystem) är nära sammankopplade och ömsesidigt beroende.
Detta angreppssätt mobiliserar flera sektorer, discipliner och samhällsnivåer för att samarbeta kring att främja välmående och hantera hot mot hälsa och ekosystem. Samtidigt adresserar det gemensamma behov av rent vatten, energi och luft, säker och näringsrik mat, åtgärder mot klimatförändringar och bidrag till en hållbar utveckling.
One Health är ett begrepp som erbjuder en holistisk syn på hälsa och utgör ett viktigt forskningsområde där SLU:s forskning och expertis bidrar med ny och betydelsefull kunskap, både nationellt och globalt. One Health tar upp hälsofrågor i gränslandet mellan djur, människor och ekosystem och kräver ett tvärvetenskapligt angreppssätt.
Idag står vi inför många avgörande hälsofrågor för människor, djur och våra ekosystem, såsom ökad spridning av infektionssjukdomar och antibiotikaresistens, förlust av biologisk mångfald och klimatförändringar. Att lösa de komplexa utmaningar vi står inför kräver samarbete mellan forskare från olika discipliner. SLU bidrar med viktig kunskap inom flera ämnesområden, såsom veterinärmedicin, agronomi, ekonomi, biologi, ekologi, vatten, skog och samhällsvetenskap.